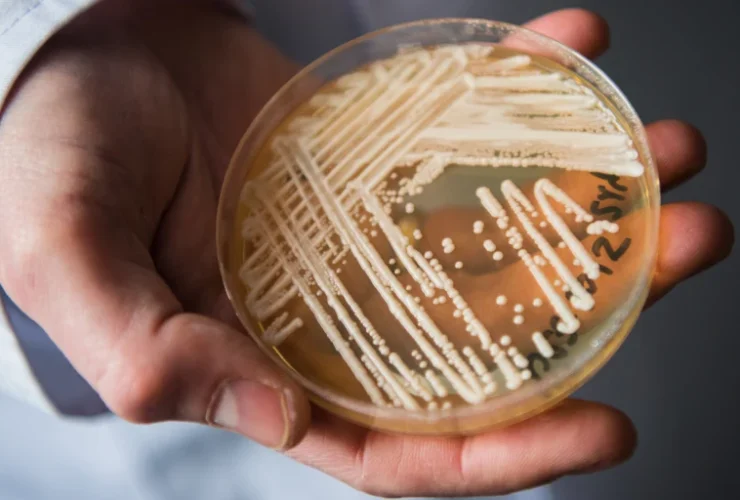

Candida overgrowth is something that can creep up on you. Your digestion is off one day and all of a sudden you are fighting fatigue, cravings, or skin problems with no obvious reason why. A lot of people start looking for ...
Botanical-based body washes stand out as a better option in a society more and more looking for mild but efficient personal care products. Beyond strong detergents and synthetic additions, these products use nature’s power to both cleanse and nurture the ...
If you’re in the fitness and athletics field, performance, recovery, and health are most important to you. While the majority of supplements are marketed for performance and recovery, few can provide the all-encompassing health benefits of Shilajit. Shilajit is a ...
Men’s mental health is often discussed separately from physical health, yet the two are closely linked in ways that can have profound effects on daily life. While struggles with anxiety or depression might be visible through changes in mood or ...
In an age where the quest for beauty often leads to a myriad of aesthetic services, Blue Illusion Beauty stands out as a beacon of holistic well-being. Nestled in the vibrant heart of California, this beauty spa in San Diego, ...
A fractional CO2 laser is a newer technology that has become extremely popular in the past few years. In a nutshell, it’s a type of laser that uses a fraction of the energy of other types of lasers to achieve ...
Sustanon 250 is a clear pale yellow liquid for injection to induce the testosterone in your body; testosterone is nothing but a male hormone produced by testicles, also known as an androgen. Testosterone plays a significant role in men for ...
Your soul is reflected in your smile. We, on the other hand, do very little to take care of our teeth. We assume that we are doing our part if we brush our teeth every day. We go through ...
According to research and data provided by cancer.gov, there will be an estimated 1,806,590 new cases of cancer diagnosed in the United States in 2020. Of that number, an estimated 606,520 will succumb to cancer or as a result of ...
Many agrees that the idea of a staycation is that to be in full holiday mood and vibe, but not having to travel until you’re outside of the city. You should be able to reach the place within a short ...